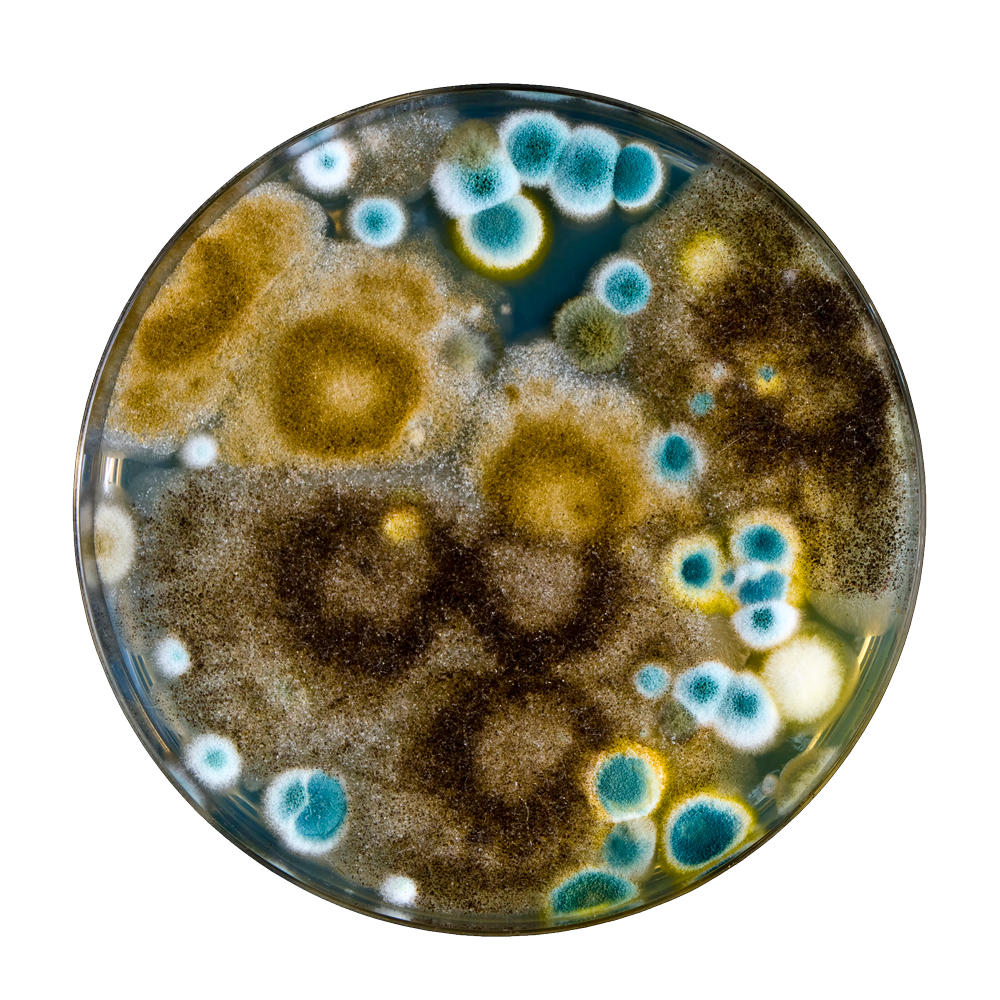

Mold Removal Expertise You Can Trust
Mold Free Solutions is a women-owned business whose staff comprises some of the most talented mold removal experts in all of Florida. We work with all insurance providers, helping our clients with their claims processes to deliver the convenience they deserve. Regardless of how bad you think your mold problem is, it can almost always be treated with the proper care and attention. Call Mold Free Solutions today for a free consultation.